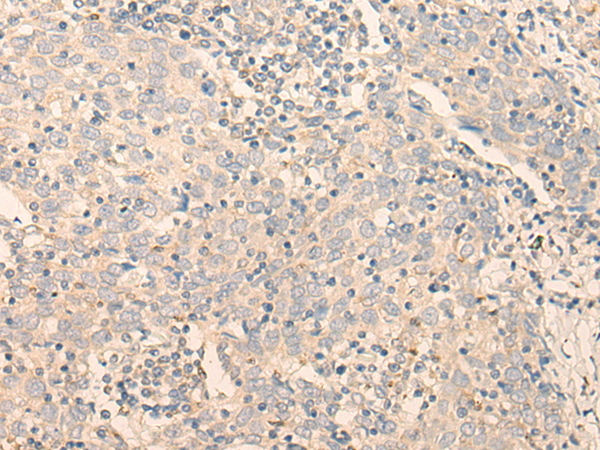

中文名稱: 兔抗GCDH多克隆抗體
|
Background: |
The protein encoded by this gene belongs to the acyl-CoA dehydrogenase family. It catalyzes the oxidative decarboxylation of glutaryl-CoA to crotonyl-CoA and CO(2) in the degradative pathway of L-lysine, L-hydroxylysine, and L-tryptophan metabolism. It uses electron transfer flavoprotein as its electron acceptor. The enzyme exists in the mitochondrial matrix as a homotetramer of 45-kD subunits. Mutations in this gene result in the metabolic disorder glutaric aciduria type 1, which is also known as glutaric acidemia type I. Alternative splicing of this gene results in multiple transcript variants. A related pseudogene has been identified on chromosome 12. |
|
Applications: |
ELISA, IHC |
|
Name of antibody: |
GCDH |
|
Immunogen: |
Fusion protein of human GCDH |
|
Full name: |
glutaryl-CoA dehydrogenase |
|
Synonyms: |
GCD; ACAD5 |
|
SwissProt: |
Q92947 |
|
ELISA Recommended dilution: |
5000-10000 |
|
IHC positive control: |
Human cervical cancer |
|
IHC Recommend dilution: |
30-150 |
購物車
幫助
021-54845833/15800441009
